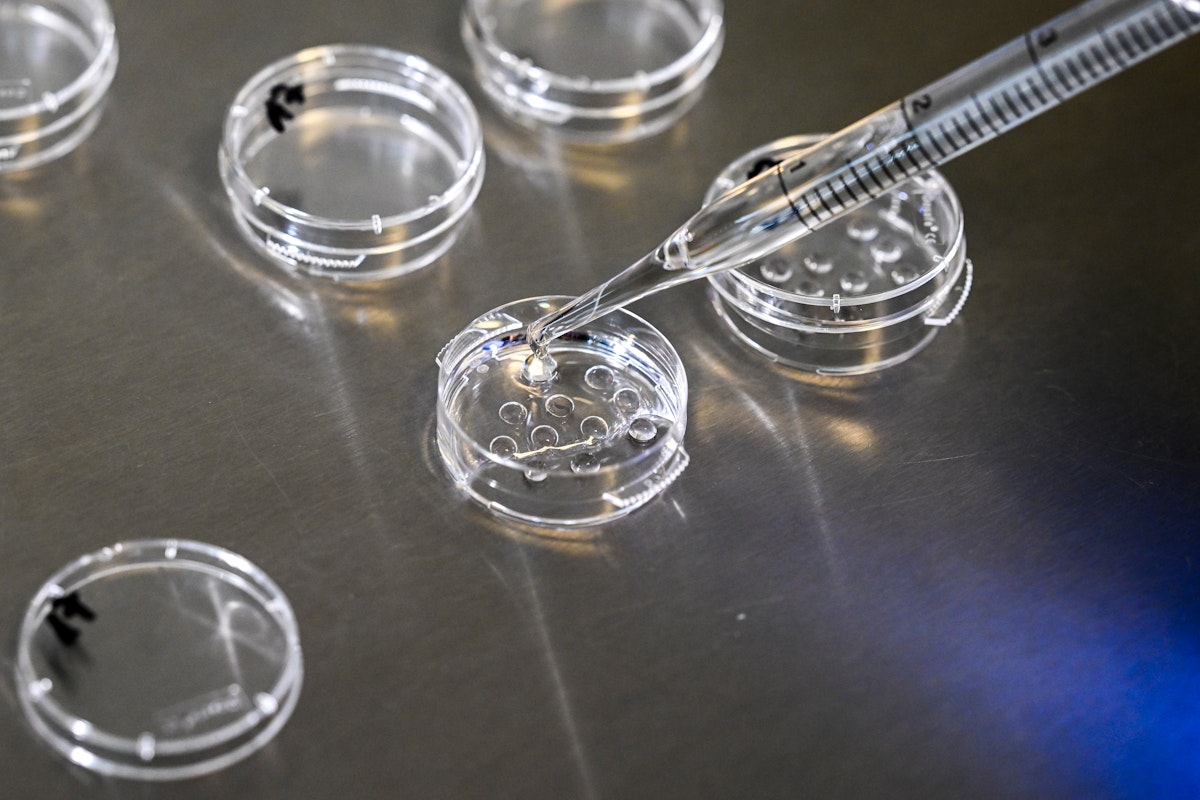
Horrific Alabama Embryo Ruling Is Still Having Tragic Effects on IVF Horrific Alabama Embryo Ruling Is Still Having Tragic Effects on IVF

Hence then, the article about horrific alabama embryo ruling is still having tragic effects on ivf was published today ( ) and is available on The New Republic ( Middle East ) The editorial team at PressBee has edited and verified it, and it may have been modified, fully republished, or quoted. You can read and follow the updates of this news or article from its original source.
Read More Details
Finally We wish PressBee provided you with enough information of ( Horrific Alabama Embryo Ruling Is Still Having Tragic Effects on IVF )
Last updated :
Also on site :
- India eases norms for investment from China – media
- Over puppy yoga? Try it with snakes.
- Court confiscates £3k from drug-dealing rapist